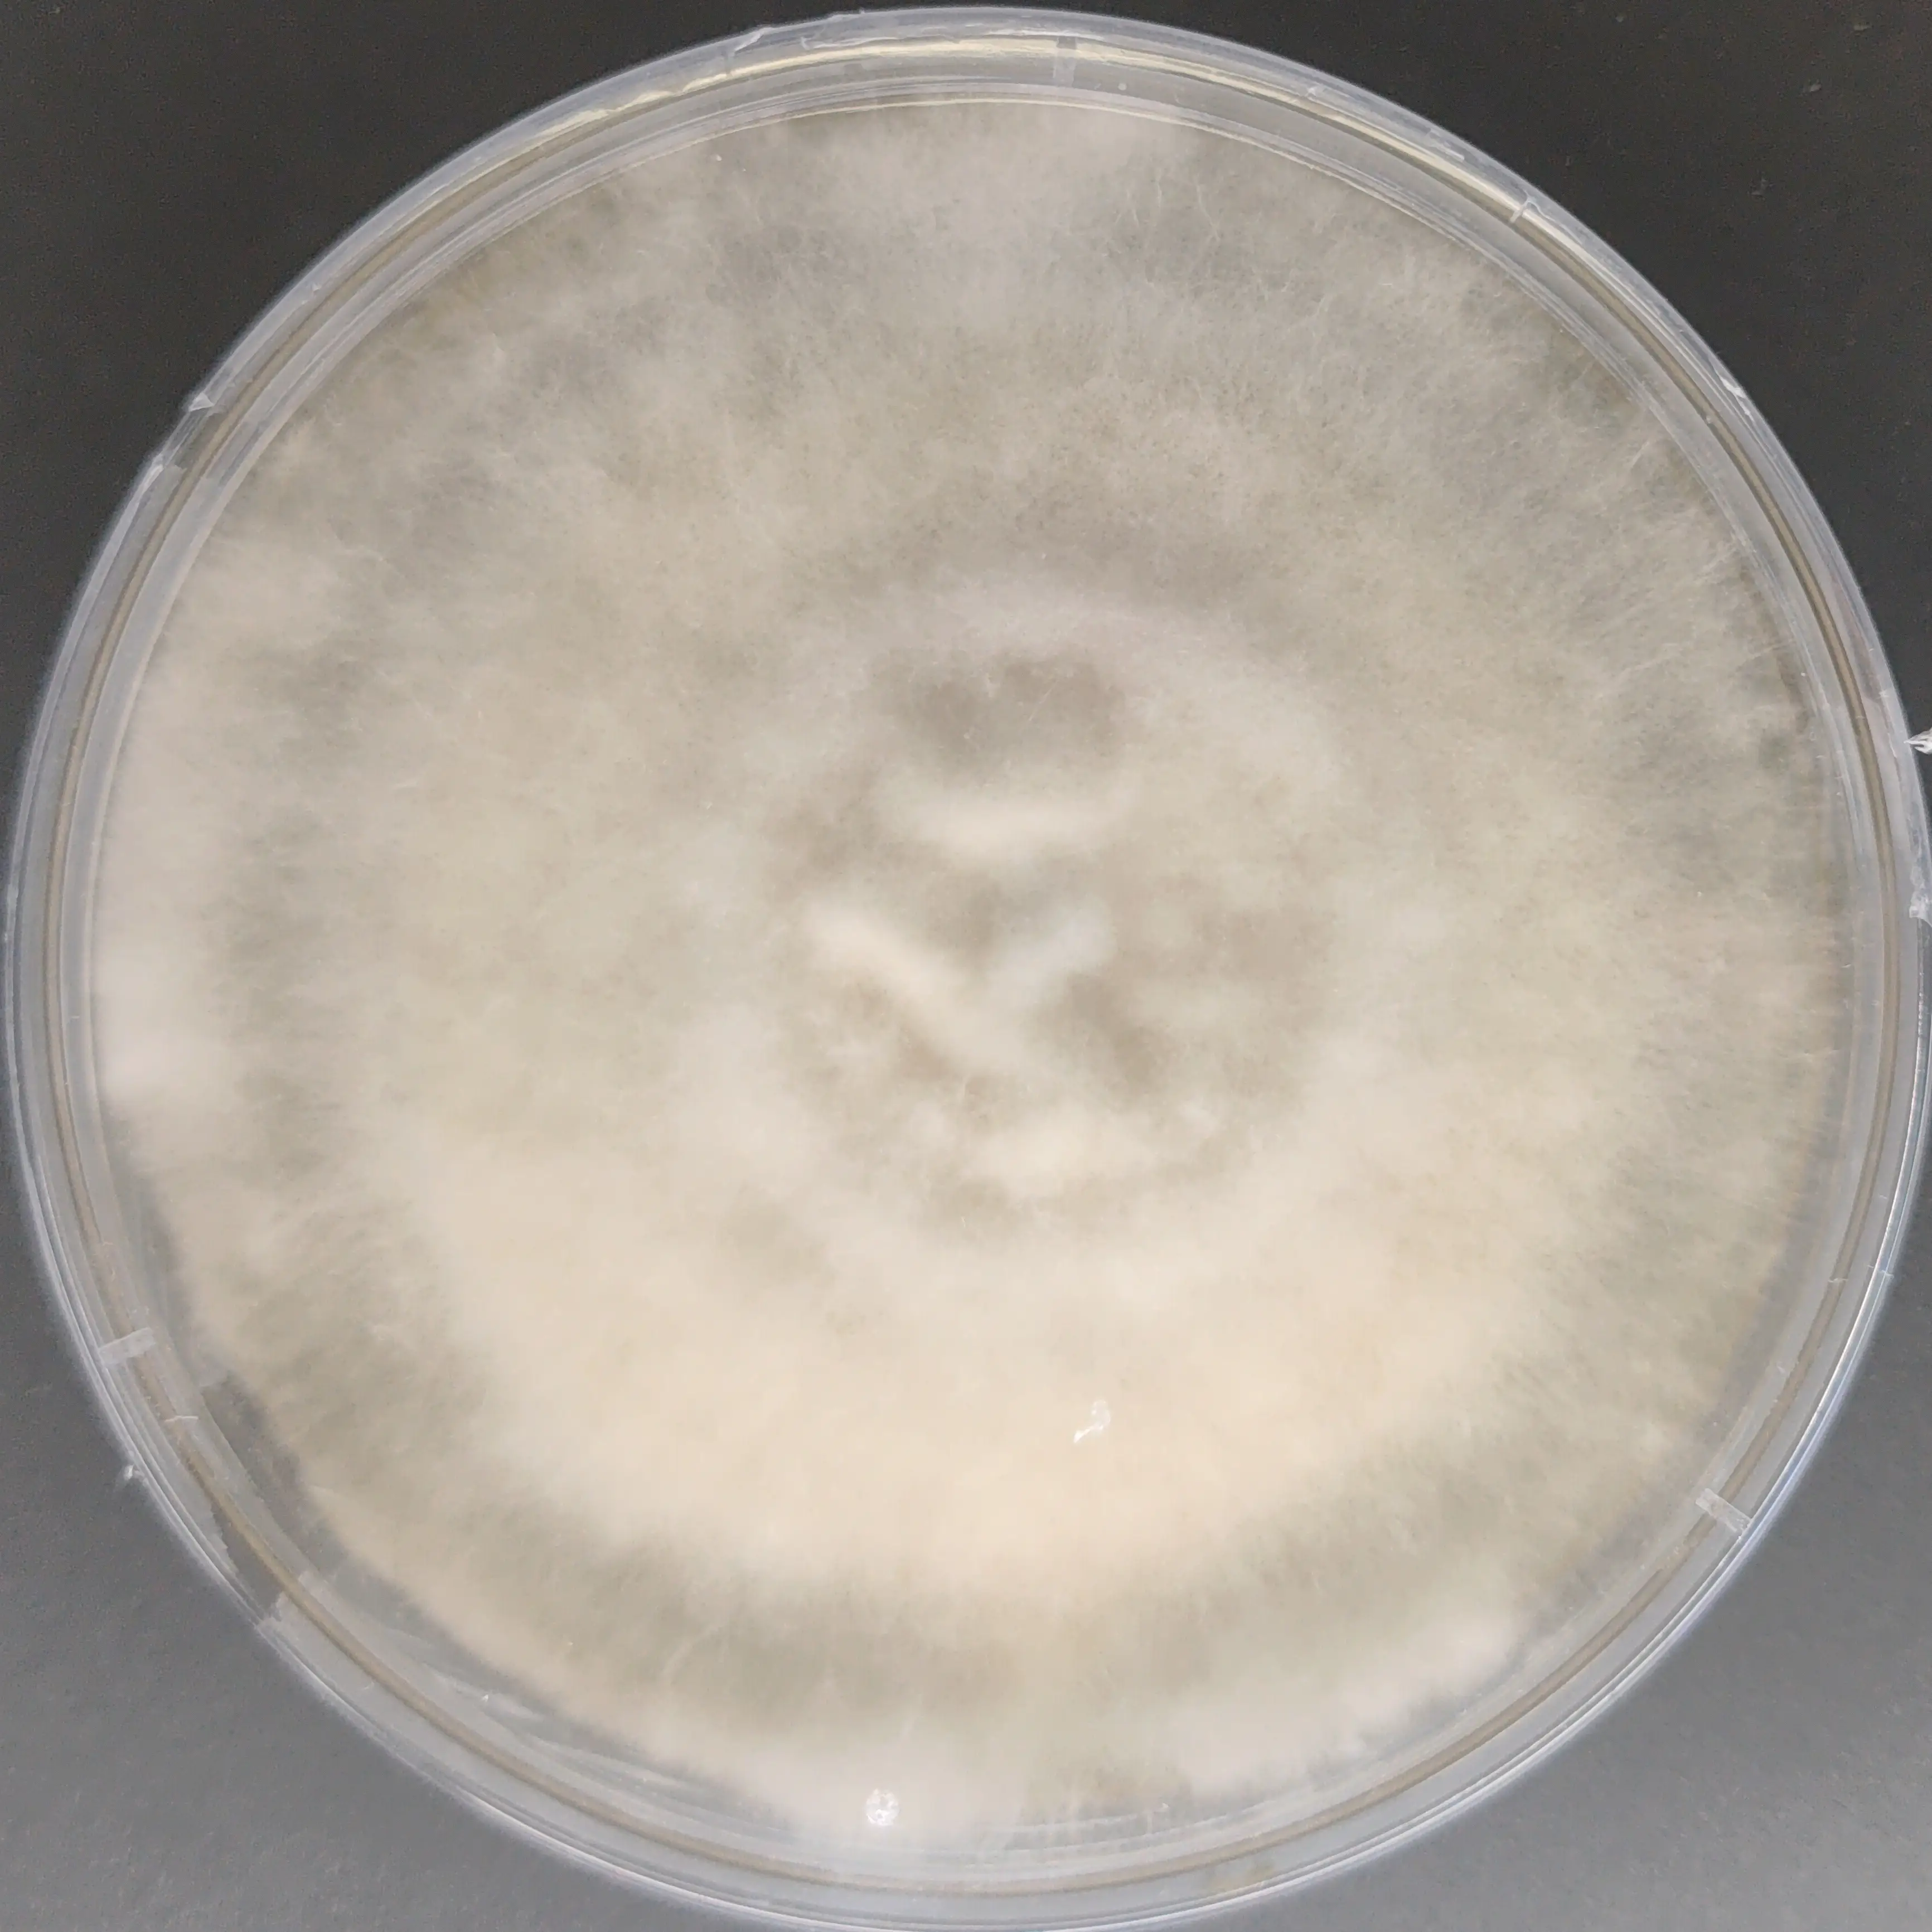
F94 Auricularia auricula 20251223.webp

Schizophyllum commune culture plate (split gill mushroom)
₹2,500.00
You’re now subscribed to price tracking for this product. We’ll notify you if the price drops.
he Schizophyllum commune (Split Gill Mushroom) Culture Plate features one of the most widely studied and resilient wood-decaying fungi, renowned for its unique split gill morphology, extreme environmental tolerance, and advanced enzyme systems. This species is a model organism in fungal genetics, mating systems, lignocellulose degradation, and industrial biotechnology.
Each culture plate contains a lab-isolated, contamination-free pure culture prepared under strict aseptic conditions to ensure stable morphology, rapid colonization, and consistent performance across a range of agar and wood-based substrates. Schizophyllum commune is particularly valued for its ability to withstand desiccation, resume growth upon rehydration, and produce bioactive compounds such as schizophyllan, a polysaccharide with pharmaceutical and biotechnological significance.
This culture is ideal for academic research, enzyme studies, biopolymer research, spawn development, and advanced mycology laboratories.
Key Features
-
Species: Schizophyllum commune (Split Gill Mushroom)
-
Culture Type: Pure culture on nutrient agar plate
-
Plate Size: 90 mm sterile Petri dish
-
Mycelial Traits: Fast-growing, highly resilient, wood-decaying
-
Applications: Research, enzyme production studies, spawn development
Handling & Storage
-
Store at 4–8 °C upon receipt
-
Use within 3 months for optimal viability
-
Intended for laboratory and research use only
🍄 Proudly prepared and stored at Agripie Agrosystem LLP, India 🇮🇳
| Weight | 0.1 g |
|---|
Only logged in customers who have purchased this product may leave a review.

Reviews
There are no reviews yet.